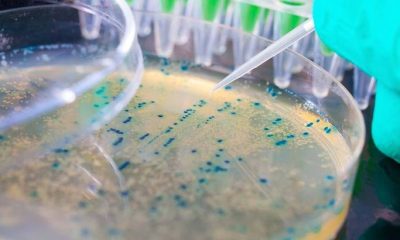

Znanstvenici su ustanovili da bakterija može razviti poseban način u odupiranju napadu kinolona Znanstvenici Sveučilišta Washington u St. Louisu objavili su rezultate novog istraživanja po kojemu...


Tvrdi sapun na umivaoniku prođe kroz mnoge ruke, većinom prljave. To ne znači da prenosi mikrobe s jedne osobe na drugu, ističe stručnjak za higijenu. Iako...

Infekcije otporne na antibiotike godišnje širom svijeta odnesu oko 700.000 života. No, ne poduzme li se ništa u vezi s tim problemom, ne razvijemo li nove...


Voće i povrće u supermarketima može biti puno bakterija pa se pobrinite da ga prije konzumacije dobro operete. Prije nego voćku primite u ruke, operite ih....


Mnogi vlasnici pasa ili mačka dopuštaju svojim ljubimcima da ih poližu po ustima. Neki vlasnici to apsolutno odbijaju, ali imaju psa koji to uporno želi napraviti....


KOLIKO ste puta posudili tuđu britvicu ili nečije škarice za nokte? Iako nas odmalena uče da je važno dijeliti, neke stvari ipak ne spadaju u tu...


PREMA mišljenju vrhunskog sportaša, plivača Michaela Phelpsa, naša se koža ljušti u bazenima, htjeli mi to ili ne. “Pa hlor to sve ubije tako da nemate...


Vjerovali ili ne, u pitanju je ručni sat. Prema najnovijem istraživanju, prosječan ručni sat sadrži čak tri puta više bakterija od prosječne wc šolje. Istraživanje je...


Kažu da uredan dom donosi i uredne misli, a za mnoge ljude to počinje pospremanjem kreveta ujutro. Ali stručnjaci kažu da to donosi više štete nego...


Kada uđe u masovnu uporabu, drastično će smanjiti nepotrebno propisivanje antibiotika Čini se da bi dani kada su liječnici pacijentima propisivali jake antibiotike dok su se...
Najnoviji komentari